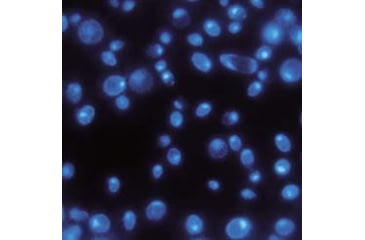
Image of GE Pc Memb Black PK-100 0.2U 47MM 111156
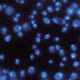
GE Pc Memb Black PK-100 0.2U 47MM 111156
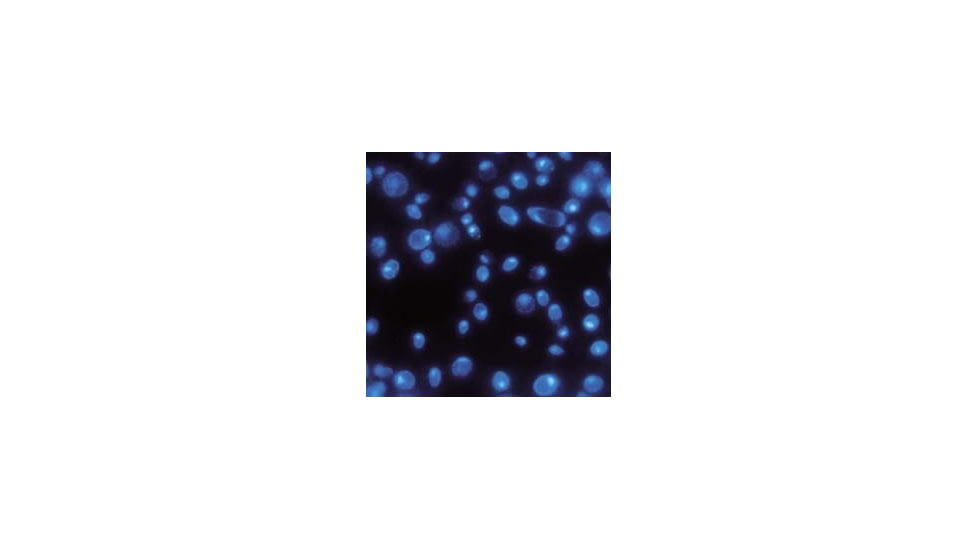
GE Pc Memb Black PK-100 0.2U 47MM 111156

Tap Tap to Zoom
Unfortunately GE Pc Memb Black PK-100 0.2U 47MM 111156 is not listed by LabPlanet.You can also explore other items in the Laboratory Filters, Laboratory membrane filters yourself to try and find the perfect replacement for you!
GE Pc Memb Black PK-100 0.2U 47MM 111156 is one of the many quality laboratory and scientific products we have to offer at very competitive pricing. GE Pc Memb Black PK-100 0.2U 47MM 111156 / 28159-310 is part of a wide selection of GE Laboratory membrane filters. Combining excellent quality with an affordable price, the GE Pc Memb Black PK-100 0.2U 47MM 111156 / 28159-310 can meet your scientific research needs while still offering a good value for a budget conscious end user. If you have any questions about any of our Laboratory membrane filters please do not hesitate to contact our customer service for further guidance.![]()
For use as a substrate for the collection and rapid analysis of bacteria, yeast, and microflora by membrane epifluorescence microscopy. Excellent for enumerating viable and non-viable bacteria in ultrapure-water systems. Filters feature extremely low autofluorescence and low absorption of acridine orange fluorochrome stain, offering high sensitivity and efficiency for analysis.
| Pore Size, µm: | 0.2 |
| Diameter, mm: | 47 |
| Whatman No.: | 111156 |
| Unit: | Pack of 100 |